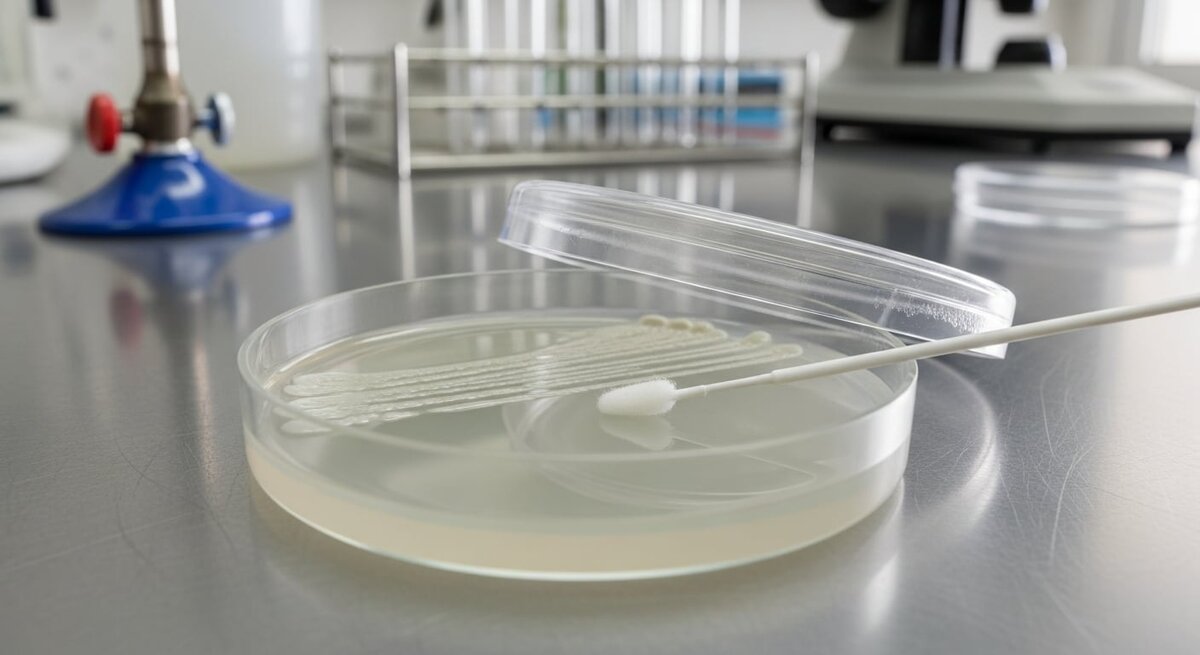

Infecciones urinarias recurrentes: qué las provoca y cómo evitar nuevas recaídas
La infección urinaria es uno de los problemas de salud más comunes a nivel mundial, provocando millones de consultas cada año y generando un alto impacto económico por los costos de diagnóstico y tratamiento.
Ante esta situación, Harvard Health Publishing publicó recomendaciones actualizadas para disminuir la frecuencia de estas infecciones y mejorar su manejo en mujeres, hombres y niños. El enfoque se centra en la detección temprana, la identificación de factores de riesgo específicos y la elección de estrategias preventivas adaptadas a cada grupo.
Detección temprana y diagnóstico correcto: pilares de la prevención
Los expertos resaltan la importancia de diferenciar el tipo de infección urinaria. Es fundamental distinguir entre una infección de la vejiga (cistitis), que se manifiesta con ardor y urgencia al orinar, y una infección renal, que puede ser grave y requiere atención médica inmediata. Esta distinción permite iniciar el tratamiento a tiempo y reducir el riesgo de complicaciones.
Entre los factores de riesgo menos conocidos para infecciones renales, se incluyen malformaciones congénitas, enfermedades crónicas y la demora en tratar una cistitis, ya que esto facilita que la infección ascienda hacia los riñones.
Importancia de la vigilancia pediátrica
En niños, la vigilancia es clave. Si un bebé o un niño presenta fiebre sin explicación, irritabilidad o cambios en la frecuencia o cantidad de orina, se recomienda acudir al pediatra lo antes posible. En casos de infecciones recurrentes, los especialistas sugieren realizar estudios adicionales y mantener un seguimiento estrecho para prevenir secuelas a largo plazo.
Prevención según edad y sexo: medidas específicas
Mujeres mayores: el uso de cremas vaginales específicas puede reducir el riesgo de infecciones urinarias al ayudar a mantener la flora bacteriana y evitar la sequedad vaginal.
Adolescentes y mujeres jóvenes: el riesgo se asocia principalmente con la actividad sexual y la higiene. Se recomienda orinar después del coito y mantener una higiene adecuada para disminuir la entrada de bacterias al tracto urinario.
Hombres adultos: el riesgo aumenta con la edad debido a factores como el agrandamiento prostático, obstrucciones urinarias, catéteres, cálculos y enfermedades crónicas. Estas condiciones favorecen la retención de orina y el crecimiento bacteriano, por lo que es esencial consultar al médico ante los primeros síntomas.
Diagnóstico preciso y manejo ante la resistencia bacteriana
Para confirmar el diagnóstico, se recomienda el uso de pruebas como el cultivo de orina, que permite identificar el microorganismo causante. En casos complejos, pueden ser necesarios estudios por imagen, como ecografías o tomografías, para evaluar si hay afectación renal o descartar otras condiciones.
Es crucial diferenciar entre infecciones urinarias no complicadas y complicadas, ya que el tratamiento varía. Las infecciones no complicadas suelen responder bien a tratamiento estándar, mientras que las complicadas pueden requerir hospitalización, antibióticos intravenosos y seguimiento médico más riguroso.
La resistencia a los antibióticos es un desafío creciente. Por ello, los especialistas recomiendan realizar un cultivo antes de iniciar el tratamiento para elegir el antibiótico más adecuado, mejorar los resultados y evitar la propagación de bacterias resistentes.
ENFERMEDADES: Qué mosquitos transmiten la malaria y cómo protegerte
Un zumbido casi imperceptible al caer la noche puede representar el inicio de un problema de salud global: la malaria. Los mosquitos que la transmiten no son solo insectos molestos, sino vectores altamente eficientes capaces de introducir parásitos directamente en el organismo -- leer más
Noticias del tema